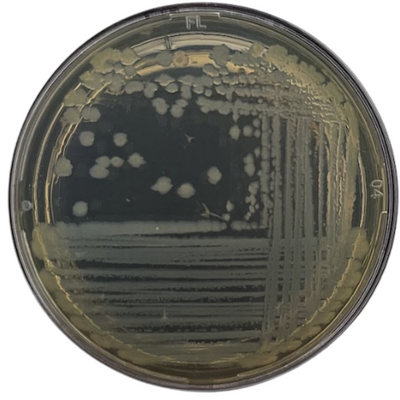

Gel de Limpeza
O detox diário que sua pele pede — e sua mente agradece.
Uma limpeza profunda que respeita a barreira cutânea e transforma o cuidado diário em um ritual de bem-estar.
Remove impurezas, poluição urbana, excesso de oleosidade e protetor solar com uma espuma cremosa que respeita a barreira da pele. Fórmula com gengibre, chá verde, juá da Caatinga e biossurfactante da Mata Atlântica, que limpa com eficácia e suavidade.
O aroma inspirado no chá verde transforma a limpeza em um ritual de bem-estar, trazendo sensação de frescor, conforto e pele equilibrada.
Resultado: pele limpa, macia e pronta para respirar.
Ouça enquanto se cuida: Por onde andei – Nando Reis
benefícios principais
Para quem busca limpeza diária eficaz, sem agredir a barreira da pele.
Indicado para todos os tipos de pele, especialmente mista e oleosa, que precisam de controle do excesso de sebo sem ressecar.
Ideal para quem convive com oleosidade, poluição urbana e sensação de pele pesada, e quer manter a pele fresca, equilibrada e confortável ao longo do dia.
Também é para quem valoriza o ritual de bem-estar: o aroma inspirado no chá verde, avaliado por técnicas de neurociência, está associado a respostas de relaxamento e sensação de equilíbrio durante a limpeza.
Dermatologicamente testado. Uso diário.
✔ Bem-estar comprovado: sensação de equilíbrio e relaxamento
✔ Limpeza gentil e eficaz
✔ Controla a oleosidade, sem efeito rebote
✔ Protege contra a polição urbana
✔ Hidrata
✔ Fortalece a barreira natural da pele
corpo e alma
Segurança da Fórmula
✔ Dermatologicamente testado
✔ Seguro para uso antes de exposição solar (não é fotossensibilizante)
Eficácia Comprovada
Resultados comprovados em 30 dias de uso diário:
✔ 100% aprovaram o produto, sem relatos de desconforto
✔ 97% sentiram a pele limpa
✔ 91% relataram controle da oleosidade, sem efeito rebote
✔ 88% notaram redução da aparência dos poros
✔ 94% perceberam a pele mais macia e com melhora da aparência geral
✔ 91% relataram mais hidratação e melhora da textura da pele
Testes realizados por laboratório independente brasileiro, com 32 participantes entre 18 e 60 anos.
Anti-poluição
Teste in-vitro com células da pele (queratinócitos) submetidas ao estresse simulado da poluição urbana comprovou que a exposição ao Gel de Limpeza promoveu o aumento de 71,6% na viabilidade dos queratinócitos humanos em comparação com células não expostas ao produto.
Teste realizado por laboratório independente brasileiro.
Sensação de Equilíbrio (por neurociência)
Uma técnica de percepção implícita do olfativo do Gel de Limpeza identificou que a fragrância do produto foi mais associada à sensação de “equilíbrio”.
Teste realizado por laboratório independente brasileiro com 35 mulheres entre 25 e 45 anos.
Relaxamento (por neurociência)
A fragrância do Gel de Limpeza foi avaliada por EEG e sinais fisiológicos: houve aumento de ondas alfa e redução de batimentos e sudorese, padrão compatível com relaxamento.
Teste realizado por laboratório independente brasileiro com 35 mulheres entre 25 e 45 anos.
composição
Aqua, Glycerin, Decyl Glucoside, Lauryl Glucoside, Acacia Senegal Gum Extract, Alcohol, Sodium Babassuamphoacetate, Xanthan Gum, Ziziphus Joazeiro Bark Extract, Camellia Sinensis Leaf Extract, Zingiber Officinale Rhizome Extract, Benzyl Alcohol, Citric Acid, Sodium Chloride, Sodium Benzoate, Potassium Sorbate, Rhamnolipids, Ethylhexylglycerin, Dehydroacetic Acid, Parfum, Limonene, Geraniol, Linalool, Citral.
✓ 74,49% natural e 98,86 % de origem natural (ISO16128)
✓ 32% de origem orgânica*
✓ 100% vegana e livre de crueldade
✓ Livre de OGM, glúten, lactose, ftalatos, parabenos, sulfatos, metais pesados, formaldeído e seus liberadores, óleo mineral e petrolatos, BHA, BHT, Triclosan e Triclocarban.
* % considera apenas os ingredientes passíveis de cultivo orgânico para o cálculo
transparencia
Fórmula
Com raízes no Brasil: 78% de origem brasileira (fontes vegetais ou minerais de terras brasileiras) e 86% dos ingredientes produzidos no Brasil — reforçando uma cadeia mais próxima, consciente e conectada ao nosso território.
Embalagem
Pensada para circularidade e menor impacto: frasco em PET 100% PCR (plástico pós-consumo) produzido pela Spiltag (empresa brasileira) e aplicador em PEAD monomaterial 100% reciclável da Aptar. As embalagens são 200% compensadas pela Polen, e o cartucho de papel é produzido pela Lito (empresa brasileira) com certificação FSC — um pacote premium que une performance, rastreabilidade e economia circular.

Gel de Limpeza

Reconhecimento global · 2026
Reconhecimento Internacional
Mintel Most Innovative 2026
Categoria: Beauty & Personal Care · Global Consumer Packaged Goods
O Mintel Most Innovative é o prêmio mais rigoroso do setor de bens de consumo no mundo. Avaliado pela equipe global de analistas da Mintel — empresa referência em inteligência de mercado presente em mais de 50 países — reconhece produtos que redefinem categorias, antecipam tendências e criam impacto real na vida dos consumidores.
"Innovation isn't just about launching something new; it's about creating meaningful change that resonates with consumers and has the potential to influence business, culture, and even society at large."
— Matt Nelson, Global CEO, MintelPor que este prêmio importa
O que torna o Gel de Limpeza
verdadeiramente inovador
Três pilares de inovação reconhecidos pela Mintel que fazem deste gel um produto único no mercado global de cosméticos.
Neurociência Aplicada
O aroma de chá verde foi avaliado por EEG (eletroencefalograma) e sinais fisiológicos. O resultado: aumento de ondas alfa e redução de batimentos cardíacos — padrão neurológico compatível com relaxamento e equilíbrio mental comprovados. Testado com 35 participantes em laboratório independente brasileiro.
Biodiversidade Brasileira
Formulado com Juá da Caatinga, Gengibre, Chá Verde e Biossurfactante da Mata Atlântica. 78% de origem brasileira e 98,86% de origem natural (ISO 16128). Uma cadeia produtiva que valoriza e preserva a biodiversidade do nosso território.
Eficácia Clínica Comprovada
Teste in vitro com queratinócitos humanos demonstrou aumento de 71,6% na viabilidade celular contra o estresse da poluição urbana. Em 30 dias de uso: 100% de aprovação, 97% sentiram a pele limpa, 91% relataram controle da oleosidade sem efeito rebote.
ingredientes em destaque
Como usar